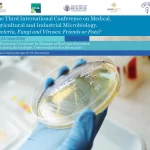

Universitatea din București și Arab Society for Fungal Conservation anunță “The Third International Conference on Medical, Agricultural and Industrial Microbiology. Bacteria, Fungi and Viruses: Friends or Foes?”, organizată în perioada 22–25 iunie 2026.
Titlurile și rezumatele trebuie trimise până la 25 mai 2026. Sunt binevenite atât prezentările orale, cât și cele sub formă de poster.
Evenimentul va avea loc în format hibrid la Platforma de Cercetare în Biologie și Ecologie Sistemică din cadrul Facultății de Biologie a UB (Splaiul Independenței 91-95, București).
Organizată de Facultatea de Biologie, Institutul de Cercetare al Universității din București (ICUB) și de Arab Society for Fungal Conservation (ASFC), în parteneriat cu MIRRI-ERIC (Microbial Resource Research Infrastructure – European Research Infrastructure Consortium) și Institutul Național de Cercetare-Dezvoltare Chimico-Farmaceutică (ICCF) București, conferința se constituie într-un forum interdisciplinar pentru explorarea modului în care progresele din cercetarea microbiană se transpun din mediul academic în aplicații practice.
Programul evenimentului va include keynote speakers de renume internațional, workshop-uri interactive, sesiuni dinamice de postere și prezentări orale, concepute pentru a stimula networking-ul, colaborarea globală și schimbul celor mai recente progrese în domeniul științelor microbiene.
Conferința reunește contribuții atât din țară, cât și din străinătate, aducând împreună specialiști de prestigiu, profesori, cercetători și academicieni din domeniul microbiologiei, precum și studenți/masteranzi/doctoranzi cu rezultate relevante în aceste domenii.
O listă a keynote speaker-ilor este disponibilă aici, iar o listă detaliată a principalelor teme ale conferinței poate fi accesată aici.
Limbile de lucru ale conferinței sunt engleza și româna.
Trimiterea lucrărilor
Titlurile și rezumatele trebuie trimise până la data de 25 mai 2026. Sunt acceptate atât prezentările orale, cât și cele sub formă de poster. Pentru pregătirea rezumatului, vă rugăm să descărcați modelul disponibil aici.
Lucrările complete trebuie trimise până la data de 10 iunie 2026. Lucrările in extenso și rezumatele prezentate la conferință vor fi publicate în Journal of Microbial Biosystems, revista științifică a Arab Society for Fungal Conservation (International Scientific Journal of Microbial Biology), indexată în Scopus și Web of Science, și arhivată în CAB Abstracts/Global Health Full-Text Repository-CABI. Lucrările trebuie să aibă maximum 10 pagini, incluzând figurile și tabelele; pentru lucrările care depășesc acest număr de pagini, autorii vor trebui să plătească taxe suplimentare. Pentru redactarea lucrării complete, vă rugăm să descărcați instrucțiunile de aici și modelul de aici.
Atât rezumatele, cât și lucrările complete trebuie trimise până la termenele menționate pe adresa events@icub.unibuc.ro.
Persoanele interesate să participe la eveniment fără o prezentare orală sau de tip poster sunt rugate să se înregistreze aici.
Workshop special
Conferința va include și un workshop special (25 iunie 2026), dedicat temei “The Microbiome Strategy: Navigating the Friend-Foe Duality in Medicine and Industry”, cu următorul program:
10:00 – 11:15: Prezentarea 1: The Molecular Switch. Analiza factorilor de virulență și a transferului de gene care transformă „prietenii” în „dușmani”.
11:15 – 12:15: Prezentarea 2: Bio-Industrial Allies. Studii de caz privind utilizarea „prietenilor” (bacterii/drojdii) pentru producția sustenabilă de medicamente și sănătatea solului.
12:15 – 12:45: Cafea & Networking. Sesiune specială în care studenții pot adresa întrebări conferențiarilor.
12:45 – 14:00: Prezentarea 3: Digital Surveillance. Un ghid practic privind utilizarea bazelor de date online (NCBI) pentru a detecta secvențe emergente de tip „dușman” în sănătatea publică.
Taxe de participare
Pentru conferință
| Categorie | Early Bird** | Regular | Ce includ? |
| Studenți* | $70 | $100 | Acces complet, materiale, pauze de cafea. |
| Cercetători * | $160 | $210 | Cele de mai sus + certificat oficial pentru tenure/ranking. |
| Cu abstract (Prof.) | $200 | $250 | Slot de prezentare și includere în volumul de rezumate (Book of Abstracts). |
| Cu articol (Prof.) | $350 | $450 | Taxă pentru procesul de peer-review și publicarea indexată. |
Pentru workshop
| Categorie | Preț (USD) |
| Studenți | $20 |
| Cercetători | $50 |
* Pentru participarea online, taxa este de 50% din total. Studenții și cercetătorii Universității din București beneficiază de o reducere de 25% din taxa de participare.
** Pentru a beneficia de taxa early bird, plata trebuie efectuată până la data de 10 iunie 2026.
*** Înregistrarea la fața locului (on-site) va presupune o taxă suplimentară de 20$.
Taxele de participare trebuie transferate către:
Titular cont: ASOCIAȚIA ALUMNI UNIVERSITĂȚII DIN BUCUREȘTI (București)
Adresa: București, B-dul Regina Elisabeta nr. 4-12, Sala M6
Cod de identificare fiscal: 29223620
Bancă: BRD Ag. Compozitorilor
Cod SWIFT: BRDEROBU
Cont IBAN: RO52BRDE410SV57544994100
Dovada plății trebuie trimisă la events@icub.unibuc.ro.
Caracteristici principale
Cea de-a treia ediție a Conferinței Internaționale de Microbiologie Medicală, Agricolă și Industrială (ICMAIM 2026) se va remarca prin:
- Platforma ideală pentru networking global
- Vorbitori de renume internațional
- Programe științifice riguros organizate și structurate
- Dezbateri și discuții științifice captivante
- Oportunitatea de a întâlni vizionari din mediul academic și industrial pentru inspirație
- Extinderea cunoștințelor și identificarea de soluții la problemele actuale
- Acces la informație, benchmarking și networking, toate în același loc
- Stabilirea de conexiuni și facilitarea colaborărilor globale
- Consiliere în carieră pentru cercetătorii aflați la început de drum și studenți
- Prezentări de postere și expoziții de talie mondială
- Întâlniri cu furnizori și distribuitori din domeniu.
Ediții anterioare ale conferinței
The First International Conference on Fungal Conservation in the Middle East and North of Africa (ICFC 2016), 18-20 October 2016, Suez Canal University, Ismailia 41522, Egypt (http://fungiofegypt.com/Conference/2016/).
The Second International Conference on Mycology in MENA (ICM-2018), 16-18 October 2018, Suez Canal University, Ismailia 41522, Egypt (http://fungiofegypt.com/Conference/2018/).